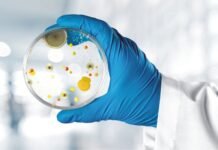
Strategies of Mold Control in Monsoon

Heat stress in dairy animals and the measures to reduce its effect on milk...
Introduction
Environmental heat stress is obviously the problem faced by the animals located in hotter (tropical) regions of the world. Heat stress not only reduces...
Effect of Early Post Hatch Feeding on the Development and Functioning of Poultry Immune...
Introduction
Paying special attention to young animal nutrition is important to achieve the full production capacity of birds and to ensure sustainable business for the...
Strategies of Mold Control in Monsoon
Abstract
Mold growth in feeds occurs when desirable temperature, oxygen, unbound water, and nutrients are available. Mitigation of these four factors prevent mold growth. Management...
Short term outlook of sluggish Maize market
The pandemic resulted in weak demand for maize against its abundant supplies. Prices for rabi crops in major producing states were reported to fluctuate...
Superdosing of Phytase – A concept to increase animal performance
Introduction
Phytic acid (Inositol Hexaphosphate- IP6) is a low solubility compound present in broiler feed. It has an anti-nutritive factor as Phosphorus is present in...
Role of Fibre in Layer Diet
In the recent past Fibre was not so much important particularly in commercial layer diet, though it was a part of feed formulation depending...
Water – the neglected nutrient
Water is the most critical nutrient for poultry. In addition to being a nutrient, water aids in digestion and absorption and respiration in birds....
Mycotoxins: A Threat to Cattle Feed Safety in Indian Dairy
Abstract:
India is the largest milk producer in the world since many years, but this is due to the number of animals present, not because...
Insect Meal as an Alternative Protein Source for Poultry
Introduction
Protein sources are second largest component of Poultry diets. Due to limited distribution and expensive nature, usually Poultry is depriving of a rich protein...
Bacteriophages helps to improve immunity during moulting
In current scenario poultry farmers are struggling to get the availability of maize & soya to feed their flocks due to lock down situations....